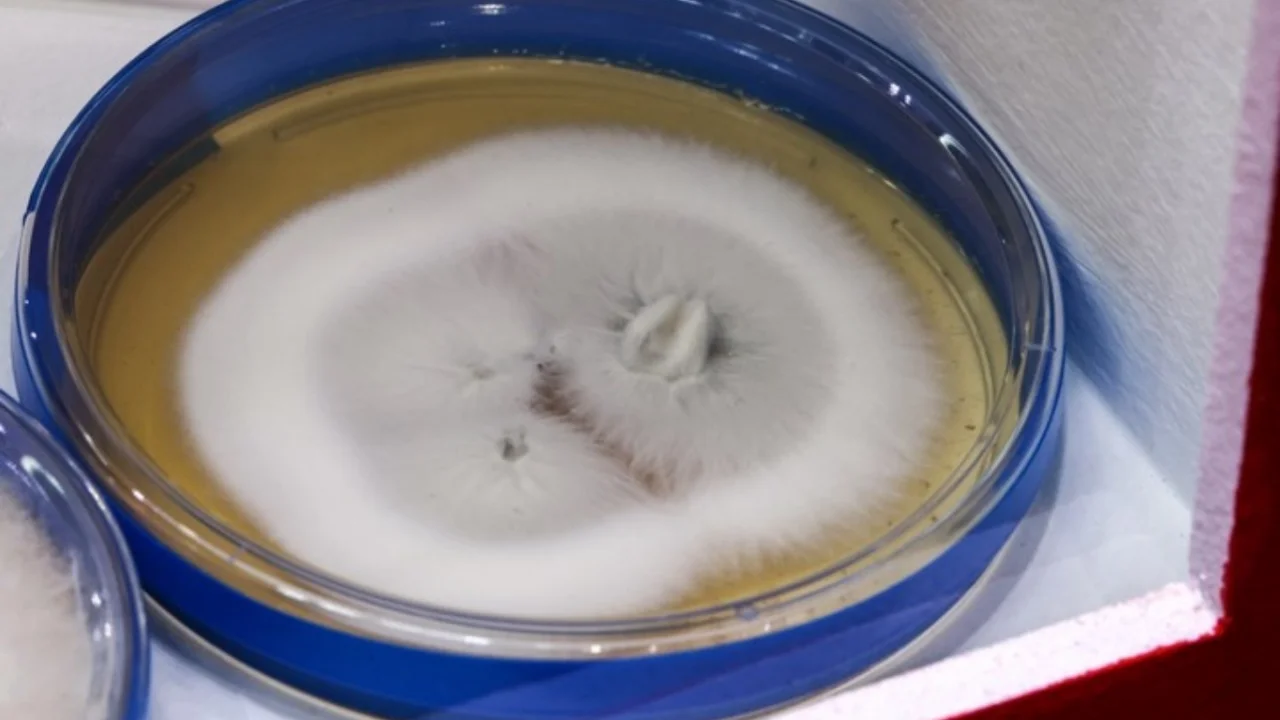
Европада хавфли “суперзамбуруғ” тез суръатда кенгаймоқда

Европада хавфли “суперзамбуруғ” тез суръатда кенгаймоқда
Европада ўта чидамли ва хавфли ҳисобланган Trichophyton indotineae замбуруғи тез суръатда тарқалмоқда. Мутахассислар уни шунчаки замбуруғ эмас, балки “суперзамбуруғ” деб аташмоқда. Бу ҳақда The Sun нашри маълум қилган.
Манчестер университетининг юқумли касалликлар бўйича эксперти Дэвид Деннинг таъкидлашича, ушбу турдаги замбуруғ танада қизариш ва кучли қичишиш билан кечадиган тошмаларни келтириб чиқаради. Дастлабки белгилари эса асосан сон ва думба қисмида кузатилади.
Нашр маълумотига кўра, Буюк Британияда охирги уч йил ичида Trichophyton indotineae билан касалланиш холатлари деярли 500 фоизга ошган. Инфекция одамдан одамга тўғридан-тўғри муносабат, ифлосланган буюм ва юзалар орқали, шунингдек, жинсий алоқа орқали юқиши мумкин.
Деннингнинг айтишича, агар замбуруғ тарқалиши шундай суръатда давом этса, у яқин йилларда жаҳон миқёсида жиддий муаммога айланиши мумкин.
“Zamin”ни Telegram'да ўқинг!